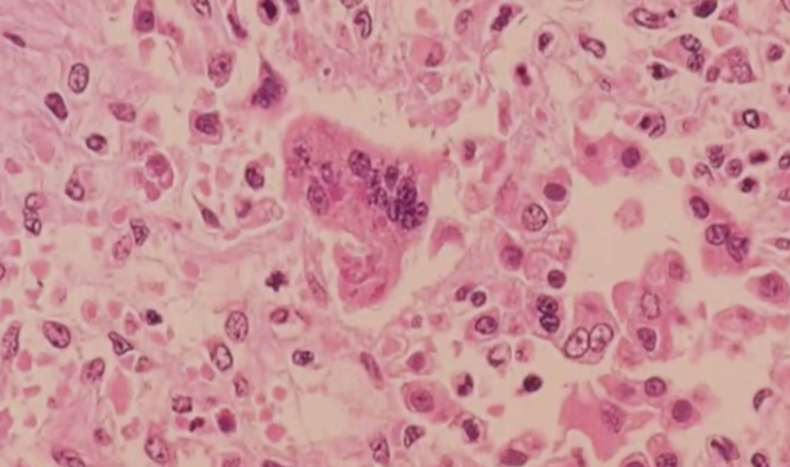
sarampion.png

Alcanzaste el límite de 40 notas leídas
Para continuar, suscribite a americateve. Si ya sos un usuario suscripto, iniciá sesión.
SUSCRIBITE- Home
- Vivir Mejor
Alerta sobre brote de sarampión
Las autoridades sanitarias han emitido una alerta debido a un brote de sarampión.
¿Querés estar informada/o las 24hs?
Suscribite a nuestro Newsletter